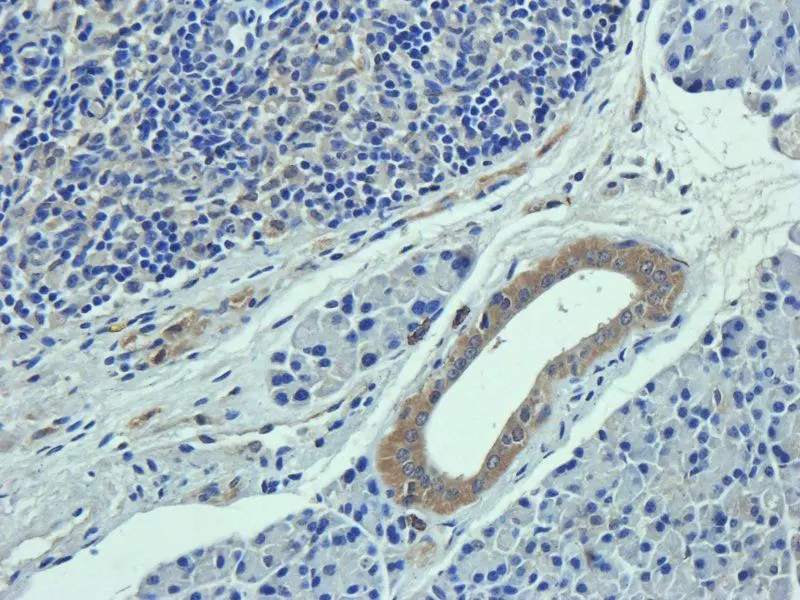
IHC-P image of mouse lymph node tissue using Collagen I antibody (5 ug/ml)

You have no items in your shopping cart.
Collagen: Strengthening your vital research
Collagen Background
Collagen is the most abundant protein in the human body, accounting for nearly a third of protein composition, with at least 16 different isoforms; it can be observed in nearly all tissues. Collagen plays a vital role as a structural protein in connective tissues such as the tendons, ligaments, and skin. It provides tensile strength and elasticity, often working alongside other important proteins such as keratin and elastin. Its abundance and variety in form and function make it an interesting protein worthy of research.
Collagen Structure
The shape and structural properties of collagen are the result of its triple-helical α-domains. In classical collagen, a single triple-helical domain comprises nearly 95% of the molecule. The correct folding of each of these chains requires a glycine residue at every third position in the polypeptide chain.
Each α-chain is composed of multiple triplet sequences of Gly-Y-Z. Y is usually proline and Z is predominantly hydroxyproline. The presence of hydroxyproline at the Y position likely contributes to the stability of collagen. These three α-chains are then twisted around one another in a rope-like manner to produce the tightly packed triple-helical structure of collagen. The interaction of α-chains is stabilized via interchain hydrogen bonding.
[Image of collagen triple helix structure]
Immunohistochemical staining of paraffin embedded rat skin tissue using Collagen III antibody (2.5 ug/ml) - orb322981.
Collagen Function
Type | Function | Associated Disease |
|---|---|---|
Collagen I | Accounts for 90% of your body's collagen, made of densely packed fibres. It provides structure to skin, bones, tendons, fibrous cartilage, connective tissue, and teeth. | Osteogenesis imperfecta (Brittle Bone Disease) - A disorder that results in fragile bones that break easily. It's typically present at birth. |
Collagen II | Made from more loosely packed fibres, it is found in elastic cartilage, which cushions joints. | Chondrodysplasias - A group of conditions that affect skeletal development and growth. The conditions are often linked to dwarfism. |
Collagen III | Secreted by fibroblasts and other mesenchymal cell types, making it a major player in a variety of inflammation-driven pathologies such as lung injury, viral and nonviral liver diseases. | Atopic Dermatitis - The most common type of eczema, a condition that makes the skin red and itchy. |
Collagen IV | The main collagen type found in the basement membrane. It is a network-forming collagen that underlies epithelial and endothelial cells, functioning as a barrier between tissue compartments. | Ehlers-Danlos Syndrome - A group of conditions that cause very flexible joints and stretchy, fragile skin. |
Featured Monoclonal Antibodies
Catalog # | Target | Host | Reactivity |
|---|---|---|---|
Collagen I | Mouse | Human | |
Collagen III | Mouse | Human | |
Collagen IV | Mouse | Human |
Featured Polyclonal Antibodies
Catalog # | Target | Host | Reactivity |
|---|---|---|---|
Collagen I | Rabbit | Human | |
Collagen I (Unique) | Rabbit | Gallus | |
Elastin | Rabbit | Human | |
Collagen IV | Rabbit | Bovine |
Top-Selling ELISA Kits
Catalog # | Target | Reactivity |
|---|---|---|
Collagen I | Human | |
Collagen I | Mouse | |
Collagen II | Human | |
Collagen IV | Human |
High-Demand Proteins & Peptides
Catalog # | Target | Type | Reactivity |
|---|---|---|---|
Collagen I | Protein | Bovine | |
Collagen III | Protein | Human | |
Collagen I | Peptide | Multiple | |
Collagen IV | Peptide | Human, Mouse, Rat |